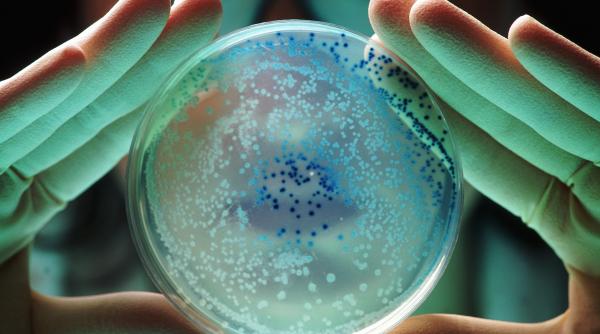
Bacteria Pseudomonas, explicată după depistarea în apa de la Spitalul de Copii Iași

La Spitalul „Sf. Maria” din Iași, probele de apă au indicat prezența bacteriei Pseudomonas aeruginosa peste limitele admise. Microorganismul se găsește în sol și apă și poate provoca infecții grave la pacienți vulnerabili, mai ales copii și persoane imunodeprimate. Specialiștii explică modul de transmitere, riscurile clinice și măsurile necesare pentru limitarea contaminării în mediul spitalicesc.
Sursa principala: Antena3.ro.
Articol adaptat de redactia Ziare pe Scurt.